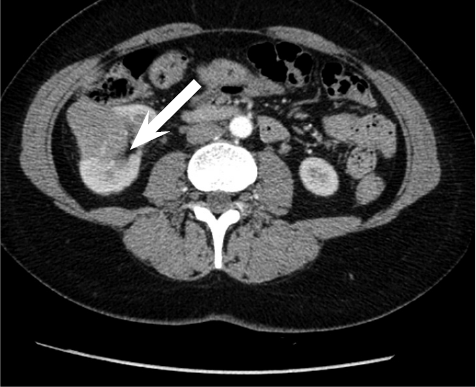

Lietuvos chirurgija ISSN 1392–0995 eISSN 1648–9942
2022, vol. 21(3–4), pp. 221–228 DOI: https://doi.org/10.15388/LietChirur.2022.21.69
Embolization of Renal Pseudoaneurysm Following Partial Nephrectomy of Localized Tumour and Preserving Renal Function: Clinical Case and Review of Literature
Giedrius Ledas
Faculty of Medicine, Vilnius University, Vilnius, Lithuania
E-mail: giedriusledas@gmail.com
Jurijus Makevičius
Clinic of Gastroenterology, Nephrourology and Surgery, Institute of Clinical Medicine, Faculty of Medicine, Vilnius University, Vilnius, Lithuania
E-mail: mak.jurijus@gmail.com
Marius Kurminas
Department of Radiology, Nuclear Medicine and Physics of Medicine, Faculty of Medicine, Vilnius University, Vilnius, Lithuania
Vilnius University Hospital Santaros Klinikos, Vilnius, Lithuania
E-mail: marius.kurminas@santa.lt
Arūnas Želvys
Clinic of Gastroenterology, Nephrourology and Surgery, Institute of Clinical Medicine, Faculty of Medicine, Vilnius University, Vilnius, Lithuania
Vilnius University Hospital Santaros Klinikos, Vilnius, Lithuania
E-mail: arunas.zelvys@santa.lt
Marius Miglinas
Clinic of Gastroenterology, Nephrourology and Surgery, Institute of Clinical Medicine, Faculty of Medicine, Vilnius University, Vilnius, Lithuania
Vilnius University Hospital Santaros Klinikos, Vilnius, Lithuania
E-mail: marius.miglinas@santa.lt
Feliksas Jankevičius
Clinic of Gastroenterology, Nephrourology and Surgery, Institute of Clinical Medicine, Faculty of Medicine, Vilnius University, Vilnius, Lithuania
Vilnius University Hospital Santaros Klinikos, Vilnius, Lithuania
E-mail: feliksas.jankevicius@santa.lt
Abstract. Surgical procedures in highly vascularized renal parenchyma sometimes can cause iatrogenic vascular complications. Although incidence renal pseudoaneurysms after partial nephrectomy is low, around 1%, clinical presentation of these patients can be quite severe – hematuria, lumbar pain, dizziness, weakness. Prompt and precise diagnostics and treatment are essential. Ultrasound and Computed Tomography are two most common diagnostic approaches for the assessment of pseudoaneurysms or arteriovenous fistulas following partial nephrectomy. Endovascular selective microcoil embolization is a safe and effective kidney-preserving procedure for treating iatrogenic vascular complications. Although when embolizing renal arteries some of renal parenchyma loses perfusion and becomes fibrotic, no significant decrease in renal function in early post-embolization period was noted. Comparing open surgery to endovascular treatment of pseudoaneurysms, latter one allows shorter average hospital stay and less frequent cardiac and peripheral vascular complications. The article discusses a case of a patient that had developed renal pseudoaneurysm after partial nephrectomy. During a routine check-up of a middle-aged woman a presumable renal cyst was found. On more throughout examination the cyst was ruled as a tumour and partial nephrectomy was performed. After 12 days from surgery patient was admitted to hospital complaining macrohematuria, lower abdomen pain, episodic right-side ache. Urgent contrast enhanced computed tomography was performed, which confirmed that patient was bleeding from the operated kidney. Patient was admitted to interventional radiology departament and perform embolization of bleeding vessel. After embolization of pseudoaneurysm, bleeding was controlled and patient was completely treated.
Key words: pseudoaneurysm, kidney, treatment, embolization, partial nephrectomy.
Pooperacinės pseudoaneurizmos, susidariusios atlikus inksto parenchimą tausojančią rezekcinę operaciją, gydymas embolizacijos metodu: klinikinis atvejis ir literatūros apžvalga
Santrauka. Gausiai vaskuliarizuotoje inkstų parenchimoje chirurginės procedūros gali sukelti jatrogeninių kraujagyslinių komplikacijų. Atlikus inksto rezekciją, kraujagyslinių komplikacijų dažnis yra žemas (apie 1 proc.), tačiau pacientų klinika gali būti gana ūmi (pasireiškia hematurija, juosmens skausmas, svaigimas, silpnumas), todėl šiems pacientams gydyti itin svarbi greita ir tiksli diagnostika. Du pagrindiniai diagnostiniai metodai, taikytini atlikus inksto rezekciją, siekiant įvertinti pseudoaneurizmas ar arteriovenines fistules, – ultragarsas ir kompiuterinė tomografija. Gydant jatrogenines kraujagyslines komplikacijas, saugi ir efektyvi procedūra, išsauganti inkstų funkciją, – selektyvi endovaskulinė embolizacija mikrospiralėmis. Embolizuojant inkstų arterijas, dalis parenchimos netenka perfuzijos ir perauga fibroziniu audiniu, tačiau inkstų filtracinė funkcija ankstyvuoju poembolizaciniu laikotarpiu statistiškai reikšmingai nesumažėja. Palyginus atvirąjį chirurginį gydymą ir endovaskulinį pseudoaneurizmų gydymą, galima teigti, kad pastarasis gydymo būdas lemia trumpesnę pacientų gydymo ligoninėje trukmę, jam būdingas mažesnis širdies ir periferinių kraujagyslių komplikacijų dažnis. Straipsnyje aptariamas klinikinis atvejis, kai, atlikus inksto rezekciją, pacientei susiformavo inksto pseudoaneurizma. Inksto rezekcija pacientei atlikta dėl darinio inkste, rasto rutininio patikrinimo metu. Kaip paaiškėjo vėliau, darinys buvo ribinio piktybiškumo. Praėjus 12 dienų po operacijos, pacientė pateko į ligoninę, nes šlapime pastebėjo kraujo, skaudėjo apatinę pilvo dalį, protarpiais maudė dešinį šoną. Atliktas skubus kompiuterinės tomografijos kontrastinis tyrimas parodė kraujavimą iš operuoto inksto. Pacientė perkelta į intervencinės radiologijos skyrių, kur atlikta kraujuojančios kraujagyslės embolizacija. Atlikus embolizaciją, kraujavimas sustabdytas, pacientė visiškai išgydyta.
Reikšminiai žodžiai: pseudoaneurizma, inkstas, gydymas, embolizacija, inksto rezekcija, onkologija.
Received: 2022/05/02. Accepted: 2022/07/10.
Copyright © 2022 Giedrius Ledas, Jurijus Makevičius, Marius Kurminas, Arūnas Želvys, Marius Miglinas, Feliksas Jankevičius. Published by Vilnius University Press. This is an Open Access article distributed under the terms of the Creative Commons Attribution Licence, which permits unrestricted use, distribution, and reproduction in any medium, provided the original author and source are credited.
Introduction
During recent years whole medicine is moving to minimally invasive medicine, with goals to preserve patients’ healthy tissues, reduce pain, have less complications and shorten hospital [1]. Partial nephrectomy is one of the examples of minimally invasive surgery, often performed laparoscopic and used for treating well-contained renal tumours [2].
The increased number of performed partial nephrectomies means higher number of iatrogenic vascular complications [3]. These complications often form specifically in kidneys due to highly vascularized renal parenchyma. Most frequent vascular complications are arteriovenous fistula and pseudoaneurysm, with latter being more common. Other possible causes of vascular complications occurrence include abdominal injuries and congenital defects [4].
Most common clinical presentation of iatrogenic vascular complication is hematuria. Some patients may also report lumbar pain, general fatigue and weakness. If macrohematuria is present patients may develop hemodynamic disorders, therefore these patients should be evaluated quickly and precisely.
According to algorithms, ultrasound imaging is in the first place for evaluation of suspected postoperative and trauma induced iatrogenic vascular complications. However, specialists and machinery needed for this evaluation may be not always available. Second best option is computed tomography with contrast enhancement. This method is used frequently due to its objectivity, precision and availability. Finally, patients can be referred for angiography with a possibility of simultaneous embolization of iatrogenic vascular complications.
This paper discusses a case of a patient diagnosed with a renal pseudoaneurysm after a partial nephrectomy, who was treated with endovascular embolization in the Department of Radiology and Nuclear Medicine.
Case report
A 52 year old woman arrived at a hospital for a routine health check-up. Abdominal ultrasound revealed a 4.5 cm diameter lesion in the right kidney. Patient was directed to perform a contrast-enhanced computed tomography (CT), which was performed to specify the nature of the formation. CT found 49 mm x 34 mm cyst in the middle-lower portion of right kidney with septum and contrast accumulation (Figure 1), it was classified as Bosniak III and partial nephrectomy was chosen as a main choice of treatment.
Figure 1. A contrast-enhanced Computed Tomography of abdomen was performed (a 49 mm x 34 mm cyst in the middle-lower portion of right kidney with septum and contrast accumulation was found (white arrow)
Partial resection of the lower lobe of right kidney was performed. Before surgery blood creatinine was 83 µmoL/L and estimated glomerular filtration rate (eGFR) was 73 mL/min/1.73 m2. During operation, a 45 mm size capsule deforming lesion of the right kidney was visualised and removed from the patient. Hystologic diagnosis revealed the lesion to be renal chromophobic carcinoma (G1, according to Paner modified chromophobic carcinoma scheme), pT1a (35 mm, kidney limited lesion). Carcinoma structures were 0,1 mm distance from parenchyma resection borders, confirming that radical resection of the tumor was achieved. Five days after partial nephrectomy patient was feeling satisfactorily, was urinating normally and did not mention any pain in the lumbar region. Renal function was normal, creatinine was 86 µmoL/L and eGFR was 70 mL/min/1.73 m2.
After 11 days from operation patient noticed red urine and started to feel pain in lower right abdomen.
In the emergency department, patient’s examination found right hydronephrosis due to blood clot and hemathoma and hematuria with urine bladder tamponade. Laboratory tests revealed anemia (hemoglobin was 0.86 g/dL) and renal function deterioration (creatinine increased till 100 µmoL/L and eGFR was 58 mL/min/1.73 m2).
Cause of hematuria had to be determined, therefore urgent contrast enhanced computed tomography was performed (Figure 2) – contrast extravazation was found on the lower third of the right kidney (area of surgery), along with subcapsular hemathoma. Right hydroureteronephrosis and fluid in pelvis were observed. Blood clots and a small amount of contrast in the bladder were seen.

Figure 2. Contrast extravazation was found on the lower third of the right kidney (white arrow), subcapsular hemathoma (grey arrow)

Figure 3. Blood in bladder (grey area in bladder), small amount of contrast in the bladder (bladder is full, with catheter inside it)
Patient was admitted to interventional radiology departament for embolization of the bleeding vessel int resected part, before it drainage and lavage of urinary bladde was perfomed and hemotransfusion started.
Right femoral artery was punctuated under local anesthetic. Inferior segmental artery was selectively catheterized and pseudoaneurysm was visualized. A microcatheter was inserted into segmental branch (Figure 4).

Figure 4. Renal pseudoaneurysm catheterized and visualized using contrast solution

Figure 5. Pseudoaneurysm embolized using 3 coils
Pseudoaneurysm was embolized with two 8 mm x 20 cm coils, an additional coil of 12 mm x 30 cm (Figure 5).
Control angiography with contrast was performed. Pseudoaneurysm was completely occluded and no longer visible (Figure 6). No extravasation was found.
After embolization, creatinine decreased till 83 µmoL/L and eGFR was 73 mL/min/1.73 m2. Pseudoaneurysm was no longer visible, as well as small segmental branches. Vascularization of renal parenchyma is reduced.
Contrast enhanced computed tomography was performed on patient as a check-up after pseudoaneurysm embolization. Scarring tissues near the lower lobe of resected right kidney and ~3 milimetres size hyperdensive lesion were found. Renal collectoric systems were not spread out. No signs of recidyves/progression of renal cell carcinoma were found.

Figure 6. Control angiography after embolization (pseudoaneurysm is no longer visible; small segmental branches in renal parenchyma are not visible)
Discussion
Chromophobe renal cell carcinoma
Cromophobe renal cell carcinoma (chRCC) is the third most common type of renal cell carcinoma (RCC) with distinct biology compared to other kidney cancer subtypes. The heterogeneity between the RCC subtypes is associated with noticeable differences in tumor aggressiveness and risk for the development of metastatic disease. Comparing chromophobe renal cell carcinoma to renal clear cell carcinoma, the first one metastasizes less frequently and usually the clinical presentation is less aggressive as compared to renal clear cell carcinoma. Most patients with chRCC are asymptomatic at the time of diagnosis.
Gold standard treatment of localized chRCC is surgery, which partial nephrectomy being favored by surgeons due to its advantages compared to radical nephrectomy. For tumors less than 3 cm, ablative procedures such as cryosurgery, radiofrequency, or microwave ablation are alternate options but have a relatively higher risk of local recurrence than conventional surgery [5]. Currently, there is no role for adjuvant therapy after definitive surgery for stages I–III chRCC.
Our patient was treated with partial nephrectomy due to the size of the tumor and goal to preserve renal parenchyma as much as possible.
Pathology mechanism
Partial nephrectomy is often used for treatment of renal tumors, since this procedure shows similar oncologic outcomes compared to total nephrectomy, but has lower risk of post-operative chronic renal failure [6, 7]. Renal iatrogenic vascular complications (pseudoaneurysms, arteriovenous fistulas) often form after a trauma or percutaneous urologic procedures, laparoscopic and open surgeries [3]. This is due to highly vascularized renal parenchyma. Pseudoaneurysm are local disruptions of the vascular wall leading to turbulent blood flow and hematoma formation. Walls of pseudoaneurysms are formed by only one or two of the three normal arterial walls layers, typically the adventitia alone [8]. Partial nephrectomy and percutaneous kidney biopsy are two procedures that most commonly cause iatrogenic vascular complications. Frequency of these complications after partial nephrectomy is relatively low (around 1%) [9, 10]. These complications should be taken seriously, since iatrogenic vascular lesions can lead to severe hematuria, blood loss and hemorrhagic shock. According to literature, symptoms usually appear few hours after renal surgery or procedure, but delayed presentation after a couple of weeks or months is not uncommon and may have severe consequences [11]. On other hand, patients can be completely asymptomatic and vascular malformations can be found on routine check-ups.
Diagnostics
Diagnostics of these post-operative complications should be prompt and precise, since rapidly decreasing blood hemoglobin concentration is a life-threatening situation. Unfortunately, often symptoms are unspecific – hematuria, flank pain, hypotension, weakness, and fever – or delayed in occurrence [12]. Ultrasound and CT are two most common diagnostic approaches for the assessment of pseudoaneurysms or arteriovenous fistulas following partial nephrectomy.
For suspected post-operative iatrogenic vascular complications, diagnostic algorithm includes ultrasound imaging (with or without contrast agent) in the first place. Contrast enhanced ultrasound is very helpful diagnostics tool in patients with compromised renal function, although this imaging modality is highly dependent on knowledge of the performing physician, therefore it can be not available in many institutions. Magnetic resonance imaging can also be used in patients with renal function decrease since it can give a lot of diagnostic information without the use of contrast solution.
If the findings in ultrasound are inconclusive, computed tomography with contrast agent is recommended. Computed tomography has the advantage of not only the detection of pseudoaneurysms and arteriovenous fistulas but also the diagnosis of other intra-abdominal pathologies such as hematoma or urinary retention. Contrast enhanced computed tomography is used frequently due to its objectivity, precision and availability.
In patients with severely impaired renal function, the use of nephrotoxic contrast media can pose an unacceptably high risk. Ultrasound is valuable for detecting hemorrhage and contrast enhanced computed tomography is useful to discover renal arterial pseudoaneurysm/renal arteriovenous malformation with a feature of a well-circumscribed dense collection of contrast medium or early visualization of draining veins in the arterial phase [13].
When there is a strong suspicion of a pseudoaneurysm or an arteriovenous fistula, angiography with a subsequent embolization procedure may be a straightforward approach [11].
Treatment
Conservative treatment has been ineffective in renal pseudoaneurysms/arteriovenous malformations [13]. Surgical treatment at this moment in only valuable option. Open surgical repair options include ligation, total or partial excision and patching (prosthetic or vein). Partial nephrectomy as a method of open surgical treatment of pseudoaneurysm is unfavorable since a secondary incision and resection of the affected tissue are traumatic for the patient, cause longer hospital stay and recovery period. Endovascular treatment techniques, such as embolization, coiling, and covered stents, currently are seen as a gold standard for pseudoaneurysms treatment, due to the minimally invasive nature and anticipated shorter recovery time. According to P. Barrionuevo et al., main differences between open and endovascular surgery are more frequent cardiac and peripheral vascular complications in open surgery group (2.2% vs 0.6%; P = 0.001 and 0.6% vs 0.0%; P = 0.01, accordingly), longer length of in-hospital stay (6.0 vs 4.6 days; P < 0.001) [14].
Transcatheter embolization is a promising minimally invasive method can be used for treating vascular complication that occur after partial nephrectomy [10, 11]. Multiple embolization agents can be used – gel sponge, microcoils and other. Selective microcoil embolization is a safe and effective kidney-preserving procedure for treating these complications. Technical and clinical success rates of pseudoaneurysm embolization are 100% and 96.3% respectively, with no significant decrease in renal function in early post-embolization period, although the volume of renal parenchyma does decrease [9, 13].
Embolization procedure using coils has very high successful treatment chance since procedure is eye-controlled and interventional radiologist can be sure when the targeted vessel is completely occluded. Microcoil embolization enables isolation of the vascular lesion while retaining maximal renal vascularization, thus ensuring as much preservation of the renal parenchyma as possible [10]. According to literature, after embolization volume of renal parenchyma usually decreases by around 25%, eGFR does not change [9]. Renal parenchyma loss is compensated by an increased perfusion of the remaining healthy renal parenchyma, therefore eGFR is not affected greatly. Further limitations of embolization are contrast media used when inserting the coils, which is nephrotoxic.
Conclusion
Surgical procedures in highly vascularized renal parenchyma sometimes can cause iatrogenic vascular complications to form, such as pseudoaneurysms. Although incidence of these complications is low, around 1%, clinical presentation of these patients can be quite severe – hematuria, lumbar pain, dizziness, weakness. Prompt and precise diagnostics and treatment are essential. Selective microcoil embolization is a safe and effective kidney-preserving procedure for treating iatrogenic vascular complications. Embolization leads to a significant loss of renal parenchymal volume, but not to a loss of renal function.
References
1. Sood A, Meyer CP, Abdollah F, Sammon JD, Sun M, Lipsitz SR, Hollis M, Weissman JS, Menon M, Trinh QD. Minimally invasive surgery and its impact on 30-day postoperative complications, unplanned readmissions and mortality. British Journal of Surgery 2017; 104(10): 1372–1381.
2. Deng H, Fan Y, Yuan F, Wang L, Hong Z, Zhan J, Zhang W. Partial nephrectomy provides equivalent oncologic outcomes and better renal function preservation than radical nephrectomy for pathological T3a renal cell carcinoma: a meta-analysis. Int Braz J Urol 2021; 47(1): 46–60.
3. Jain S, Nyirenda T, Yates J, Munver R. Incidence of renal artery pseudoaneurysm following open and minimally invasive partial nephrectomy: a systematic review and comparative analysis. J Urol 2013; 189(5): 1643–1648.
4. Yamaçake KGR, Lucon M, Lucon AM, Mesquita JLB, Srougi M. Renal artery pseudoaneurysm after blunt renal trauma: report on three cases and review of the literature. Sao Paulo Med J 2013; 131(5): 356–362.
5. Campbell S, Uzzo RG, Allaf ME, Bass EB, Cadeddu JA, Chang A, Clark PE, Davis BJ, Derweesh IH, Giambarresi L, Gervais DA, Hu SL, Lane BR, Leibovich BC, Pierorazio PM. Renal Mass and Localized Renal Cancer: AUA Guideline. Journal of Urology 2017; 198(3): 520–529.
6. MacLennan S, Imamura M, Lapitan MC, Omar MI, Lam TBL, Hilvano-Cabungcal AM, Royle P, Stewart F, MacLennan G, MacLennan SJ, Dahm P, Canfield SE, McClinton S, Leyshon Griffiths TR, Ljungberg B, N’Dow J, UCAN Systematic Review Reference Group; EAU Renal Cancer Guideline Panel. Systematic review of perioperative and quality-of-life outcomes following surgical management of localised renal cancer. Eur Urol 2012; 62(6): 1097–1117.
7. Volpe A, Blute ML, Ficarra V, Gill IS, Kutikov A, Porpiglia F, Rogers C, Touijer KA, Van Poppel H, Thompson RH. Renal Ischemia and Function After Partial Nephrectomy: A Collaborative Review of the Literature. Eur Urol 2015; 68(1): 61–74.
8. Hemp JH, Sabri SS. Endovascular Management of Visceral Arterial Aneurysms. Techniques in Vascular and Interventional Radiology 2015; 18(1): 14–23.
9. Strobl FF, D’Anastasi M, Hinzpeter R, Franke PS, Trumm CG, Waggershauser T, Staehler M, Clevert DA, Reiser M, Graser A, Paprottka PM. Renal Pseudoaneurysms and Arteriovenous Fistulas as a Complication of Nephron-Sparing Partial Nephrectomy: Technical and Functional Outcomes of Patients Treated With Selective Microcoil Embolization During a Ten-Year Period. Fortschr Röntgenstr 2016; 188(2): 188–194.
10. Gahan JC, Gaitonde M, Wadskier L, Cadeddu JA, Trimmer C. Renal function outcomes following selective angioembolization for iatrogenic vascular lesions after partial nephrectomy. J Endourol 2013; 27(12): 1516–1519.
11. Tinto HR, Di Primio M, Tselikas L, Rico AP, Pellerin O, Pagny JY, Sapoval M. Selective arterial embolization of life-threatening renal hemorrhage in four patients after partial nephrectomy. Diagn Interv Imaging 2014; 95(6): 601–609.
12. Kuklik E, Pyra K, Światłowski Ł, Kuczyńska M, Sobstyl J, Drelich-Zbroja A, Jargiełło T, Tsitskari M, Szczerbo-Trojanowska M. Embolization of iatrogenic renal arteriovenous fistula – a case report. J Ultrason 2018; 18(73): 170–173.
13. Guo H, Wang C, Yang M, Tong X, Wang J, Guan H, Song L, Zou Y. Management of iatrogenic renal arteriovenous fistula and renal arterial pseudoaneurysm by transarterial embolization: a single center analysis and outcomes. Medicine (Baltimore) 2017; 96(40): e8187.
14. Barrionuevo P, Malas MB, Nejim B, Haddad A, Morrow A, Ponce O, Hasan B, Seisa M, Chaer R, Murad MH. A systematic review and meta-analysis of the management of visceral artery aneurysms. Journal of Vascular Surgery 2019; 70(5): 1694–1699.